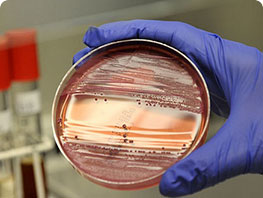

Пн.-чт.: 08.00-16.30
Пт.: 08.00-15.30
Обед: 12.00-12.30
Приемная материала:
Пн.-Чт.: до 16.30
Пт.: до 15.30
Приём срочных проб по согласованию
Сб.-Вс.: выходной
г. Тюмень,
ул. Механизаторов, 5
Многоканальный телефон:
+7 (3452) 43-03-93
+7 (3452) 43-00-69
Научно-аналитический центр:
+7 (3452) 43-05-78 (доб.134)